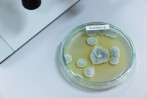

AGB - Fusion aus Reinigungstechnik und Hygienemanagement
Hauptmenü:
- HOME
- ARNE
- SISE
- SCHULUNG
- WISSENSWERT
- GUTACHTEN
- KONTAKT
- IMPRESSUM
AGB
IMPRESSUM

Sie erhalten unsere allgemeinen und besonderen Geschäftsbedingungen automatisch bei Angebotslegung oder können diese auch als Kunde unter office@arne-
Fragen zur ARNE -
office@arne-
Fragen zum sise Hygiene-
sise@arne-





HOME | ARNE | SISE | SCHULUNG | WISSENSWERT | GUTACHTEN | KONTAKT | IMPRESSUM | Generelle Seitenstruktur